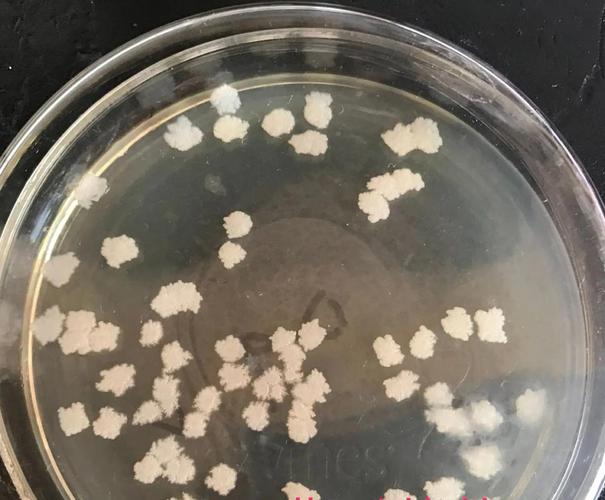

本篇文章给大家谈谈巨大芽孢杆菌芽孢形状和位置,以及巨大芽孢杆菌图对应的知识点,希望对各位有所帮助,不要忘了收藏本站喔。
细菌形成的芽孢是什么?
芽孢,也被称为内生孢子,是细菌的一种休眠体形式。芽孢在多个方面发挥着重要作用。首先,它作为分类鉴定的依据。不同种类的细菌在形成芽孢时展现出独特的特点,如形状、大小、表面特征以及与菌体的关系等,这些差异为细菌的分类和鉴定提供了重要参考。
(图片来源网络,侵删)
芽孢是细菌的一种特殊生存形式,当外界环境变得极端,如温度过高、过低,或缺乏营养物质时,细菌会进入一种休眠状态,形成芽孢。这种休眠形式使得细菌能够在恶劣环境下存活,直到环境条件恢复到适宜生存的状态。芽孢形成的过程涉及细胞结构的显著变化。
芽孢是细菌的一种休眠体,又称内生孢子。以下是关于芽孢及其作用的详细解释:芽孢的定义 芽孢是某些细菌在特定条件下形成的一种休眠结构,它允许细菌在恶劣环境中存活并保持其遗传信息。芽孢的形成是细菌对环境压力的一种适应机制,通过形成芽孢,细菌可以在缺乏营养、干燥、高温等不利条件下存活。
芽孢:某些细菌在其生长发育到一定阶段后,可在细胞内形成一个圆形的,椭圆形的抗逆性休眠体,芽孢具有极强的抗热,抗辐射,抗化学药物等的能力,细菌的芽孢是特殊的休眠体的形式,它是细菌的原生质的浓缩,含水量低,具有极强的抵抗寒冷,干旱,高温,营养缺乏等抗性,可以度过不利的环境。
(图片来源网络,侵删)
巨大芽孢杆菌的形态特征与生防特点及经济用途!
1、生防特点:强抗逆性:巨大芽孢杆菌能够形成芽孢,芽孢具有极强的抗热、抗辐射、抗化学药物和抗静水压等特殊性质,这使得它在不良环境条件下具有较强的生存能力。有效定殖与竞争:巨大芽孢杆菌能在植物根际有效定殖,并通过营养竞争来拮抗病原菌,从而降低病原菌的群体数量。
2、巨大芽孢杆菌的形态特征为杆状,形成椭圆形芽孢;生防特点是通过芽孢形成和竞争性抑制病原菌展现效果;经济用途广泛,包括制作磷细菌肥料、生物有机肥、水体处理剂及提升烟叶发酵增香效果。形态特征:巨大芽孢杆菌是一种革兰氏阳性的好氧细菌,其形态呈杆状,能够形成椭圆形的芽孢。
3、作为生物基生产葡萄糖异构酶的工业菌种,巨大芽孢杆菌在农业上被用于制作磷细菌肥料,尤其适用于生姜和兰花的种植。它能有效防治生姜细菌性青枯病和兰花炭疽病,通过芽孢形成和竞争性抑制病原菌,展现良好的生物防治效果。形态上,巨大芽孢杆菌呈杆状,形成椭圆形的芽孢,具有高度的抗逆性。
(图片来源网络,侵删)
4、巨大芽孢杆菌可以用来生产解磷固钾肥,巨大芽孢杆菌具有很好的降解土壤中有机磷的功效,是生产生物有机肥的常用菌种,也是制作水体处理剂的常用菌种,将它施用到到烟叶上对提高烟叶发酵增香效果独特。
5、蜡状芽孢杆菌的经济用途主要包括以下几个方面:生态环境维护:抗菌物质生产:蜡状芽孢杆菌能产生抗菌物质,有效抑制有害微生物的生长,对维持生态环境的平衡和稳定起到重要作用。农业应用:土壤肥力提升:它能降解土壤中的营养成分,提高土壤肥力,从而促进农作物的生长,对农业经济具有积极的推动作用。
巨大芽孢杆菌芽孢形状和位置的介绍就聊到这里吧,感谢你花时间阅读本站内容,更多关于巨大芽孢杆菌图、巨大芽孢杆菌芽孢形状和位置的信息别忘了在本站进行查找喔。
本文可能通过AI自动登载或用户投稿,文章仅代表原作者个人观点。本站旨在传播优质文章,无商业用途。如侵犯您的合法权益请联系删除。